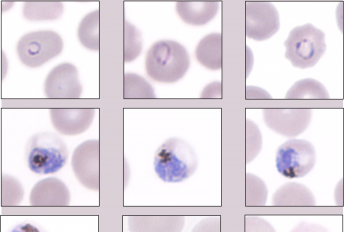

Posted on November 18, 2025
The University of Pretoria (UP) is at the forefront of the global search for new malaria treatments

Posted on November 17, 2025
Malaria may be ancient, but modern medicine has developed powerful tools to fight it.

Posted on November 12, 2025
People often ask why malaria persists despite decades of control efforts.

Posted on November 07, 2025
After a female Anopheles mosquito bites an infected person.

Posted on November 06, 2025
Each year on 6 November, SADC Malaria Day reminds us...

Posted on November 03, 2025
While the blood stage of malaria causes symptoms

Posted on October 29, 2025
How exactly does a microscopic parasite cause life-threatening damage?
Posted on October 24, 2025
When do malaria symptoms then actually begin to show?
Copyright © University of Pretoria 2025. All rights reserved.
Get Social With Us
Download the UP Mobile App